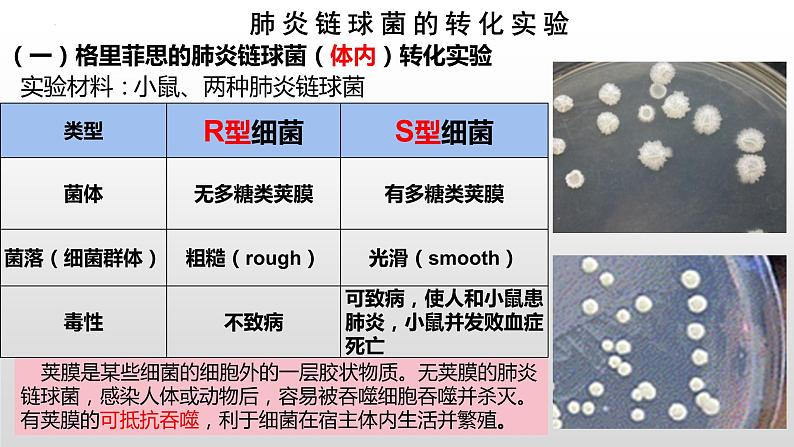
2021-2022学年高一下学期生物人教版必修二 3.1 DNA是主要的遗传物质课件（40张PPT)08

人教版 (2019)必修2《遗传与进化》第1节 DNA是主要的遗传物质多媒体教学ppt课件
展开1909年:摩尔根通过果蝇实验证明:基因位于染色体上。
19世纪中期:孟德尔通过豌豆实验证明了生物的性状是由遗传因子控制。
1903年:萨顿通过对蝗虫细胞观察得出假说:基因位于染色体上。
20世纪中期:科学家发现:染色体主要组成成分:DNA和蛋白质。
20世纪中叶,科学家发现染色体主要是由蛋白质和DNA组成的,在这两种物质中,究竟哪一种是遗传物质呢?这个问题曾引起生物学界激烈的争论。
作为遗传物质,应该具备哪些特点?
①能贮存大量的遗传信息,保证生物多样性。
③具有一定的稳定性,保持物种的稳定性。
②可以精确复制,并能传递给后代,保持亲子代之间的连续性。
④能够指导蛋白质的合成,控制生物的性状和代谢过程。
氨基酸多种多样的排列顺序,可能蕴含着遗传信息。
人们认识到DNA是由许多脱氧核苷酸聚合而成的生物大分子
没发现其他大分子有类似的结构特点。
蛋白质是生物体的遗传物质。
意识到DNA的重要性,但对DNA结构没有清晰认识。
蛋白质是遗传物质的观点占主导地位。
一、对遗传物质的早期推测
首先向“遗传物质是蛋白质”提出挑战的是谁?他做了什么实验?
证明DNA是遗传物质的实验
小鼠、两种肺炎链球菌
荚膜是某些细菌的细胞外的一层胶状物质。无荚膜的肺炎链球菌,感染人体或动物后,容易被吞噬细胞吞噬并杀灭。有荚膜的可抵抗吞噬,利于细菌在宿主体内生活并繁殖。
(一)格里菲思的肺炎链球菌(体内)转化实验
小鼠死亡,从小鼠体内分离出S型活细菌
注射加热致死的S型细菌
将R型活细菌与加热致死的S型细菌混合后注射
加热杀死的S型菌中,含有某种促R型活菌转化为S型菌的活性物质——“转化因子”
这种转化因子究竟是什么物质呢?
①对比一、二组实验现象,这说明了什么?
④什么使活R型细菌转变成活的S型细菌?
由于体内有活的S型细菌的作用。
活的R型细菌转变成了活的S型细菌。
加热杀死的S型细菌使活的R型细菌发生了转化。
②第四组小鼠为什么会死亡呢?
③第四组活的S型细菌如何出现?
S型活细菌会使小鼠死亡。
【合作探究】---寻觅“转化因子”
思考:如果你是当时的一位科学家,为了弄清楚这种转化因子到底是哪一种物质,你该如何设计这个实验?
必须将蛋白质、其他物质与DNA分开,单独、直接地观察它们的作用
但是当时的技术有限,并不能彻底提纯这些物质,因此,可以通过酶解法,将物质一个个的排除,通过观察剩余提取物的转化活性来寻找转化因子,这就是实验设计的“减法原理”(课本P46)
④运用“减法原理”,即在每个实验组人为去除某个影响因素后,观察实验结果的变化。如:在艾弗里的肺炎链球菌转化实验中,每个实验组特异性地去除了一种物质,从而鉴定出DNA是遗传物质。
自变量控制中的“加法原理”和“减法原理”
加法原理:与常态比较,人为增加某种影响因素。如:与常态比较,人为增加某种影响因素。
减法原理: 在每个实验组人为去除某个影响因素后,观察实验结果的变化。
2、艾弗里的肺炎链球菌体外转化实验
a.本实验说明什么问题?
S型细菌的细胞提取物中含有该转化因子
b.本实验起什么作用?
c.本实验能确定转化因子是哪种物质吗?
d.接下来怎么继续实验?
蛋白酶(或RNA酶、酯酶)
a.加蛋白酶的作用是什么?
去除S型细菌的细胞提取物中的蛋白质,其他物质都有
b.加蛋白酶后R型菌还是被转化说明什么问题?
说明转化因子不是蛋白质
c.同样加RNA酶、酯酶什么作用?
去除S型细菌的细胞提取物中的RNA或脂肪等物质
d.这些组实验说明什么问题
说明蛋白质、RNA和脂肪等都不是转化因子
e.本实验采用的原理是什么?
①与常态比较,人为去除某种影响因素。
②在艾弗里的肺炎链球菌转化实验中,每个实验组特异性地去除了一种物质,从而鉴定出哪种物质在发挥作用。
①与常态比较,人为增加某种影响因素。
②在”比较过氧化氢在不同条件下的分解”的实验中,与对照组相比,实验组分别作加热、滴加FeCl3溶液、滴加肝脏研磨液的处理。
a.加DNA酶的作用是什么?
去除S型细菌的细胞提取物中的DNA
b.加DNA酶后只长R型菌说明什么问题?
说明细胞提取物中的转化因子很可能就是DNA。
艾弗里等人进一步分析了细胞提取物的理化特性,发现这些特性都与DNA的极为相似,于是得出结论:DNA才是使R型细菌产生稳定遗传变化的物质,同时证明了蛋白质等不是遗传物质。
X基因吸附在R型细菌表面
R型细菌转化成S型细菌
只是少数R型细菌转化为S型细菌
R型细菌转化为S型细菌的本质是什么?
艾弗里的实验引起了人们的注意,但是,由于艾弗里实验中无法真正提取出的纯DNA(0.02%蛋白质)来进一步验证遗传物质就是DNA,因此,仍有人对实验结论表示怀疑。
那么,有没有比细菌更为简单的实验材料,还能够把蛋白质和DNA彻底分开?
1952年,赫尔希和蔡斯以T2噬菌体为实验材料,完成了另一个有说服力的实验。
T2噬菌体是一种专门寄生在大肠杆菌体内的病毒,它的头部和尾部的外壳都是由蛋白质构成的,头部含有DNA。 T2噬菌体侵染大肠杆菌后,就会在自身遗传物质的作用下,利用大肠杆菌体内的物质来合成自身的组成成分,进行大量增殖。当噬菌体增殖到一定数量后,大肠杆菌裂解,释放出大量的噬菌体。
T2噬菌体的遗传物质到底是蛋白质还是DNA呢?
蛋白质的组成元素:DNA的组成元素:
C、H、O、N 、P
T2噬菌体是一种专门寄生在大肠杆菌体内的病毒,T2噬菌体侵染大肠杆菌后,就会在自身遗传物质的作用下,利用大肠杆菌体内的物质来合成自身的组成成分,进行大量的繁殖.
三.噬菌体侵染细菌的实验
a.怎么将DNA和蛋白质分开?能不能采用减法原理将DNA和蛋白质分别除去?
不能,这样会破噬菌体结构使其失去侵染能力。
b.DNA和蛋白质在一起时有什么办法区分呢?
能不能标记C、H、O、N?
c.如何将噬菌体中的蛋白质标记上35S和DNA标记上32P?可不可以直接放在培养基中培养?
不可以,因为T2噬菌体营寄生生活,无法独立生存。故应先培养细菌,再用细菌培养噬菌体。
加入含有放射性同位素35S的甲硫氨酸
含有放射性同位素35S标记的大肠杆菌
未标记的噬菌体侵染已被35S标记的大肠杆菌
得到被35S标记的噬菌体
加入含有放射性同位素32P的脱氧核苷酸
含有放射性同位素32P标记的大肠杆菌
未标记的噬菌体侵染已被32P标记的大肠杆菌
得到被32P标记的噬菌体
那该怎么标记噬菌体呢?
可以直接用含有放射性同位素的培养基来培养噬菌体吗
不可以,噬菌体是病毒,无法单独在培养基上存活,应用含被标记的大肠杆菌培养基培养噬菌体。
大肠杆菌 + 含35S的培养基→含35S的大肠杆菌
大肠杆菌 + 含32P的培养基→含32P的大肠杆菌
T2噬菌体+含35S的大肠杆菌→含35S的T2噬菌体
T2噬菌体+含32P的大肠杆菌→含32P的T2噬菌体
培养基,是指供给微生物、植物或动物(或组织)生长繁殖的,由不同营养物质组合配制而成的营养基质。一般都含有碳水化合物、含氮物质、无机盐(包括微量元素)、维生素和水等几大类物质。
35S标记的噬菌体侵染未被标记的细菌
使吸附在细菌上的噬菌体颗粒与细菌分离
让上清液中析出重量较轻的噬菌体颗粒,而离心管的沉淀物中留下被感染的大肠杆菌
说明蛋白质未进入大肠杆菌
32P标记的噬菌体侵染未被标记的细菌
说明DNA进入了大肠杆菌
上清液放射性很低,沉淀物放射性很高。
35S标记的实验发现沉淀物中也有放射性,可能是什么原因造成的?
搅拌不充分导致部分蛋白质外壳吸附在细菌上,离心时随细菌到沉淀物中。
32P标记的实验发现上清液中也有放射性,可能是什么原因造成的?
培养(保温)时间过短,部分噬菌体还未侵染细菌;培养(保温)时间过长,部分子代噬菌体已经释放。
赫尔希和蔡斯的实验表明:噬菌体侵染细菌时,DNA进入细菌的细胞中,而蛋白质外壳仍留在细胞外。因此,子代噬菌体的各种性状,是通过亲代的DNA遗传的。DNA才是噬菌体的遗传物质
能不能说明蛋白质不是遗传物质?
通过赫尔希和蔡斯的实验,现在你清楚噬菌体侵染细菌的步骤了吗?
噬菌体借尾丝吸附在细菌表面
把DNA注入到细菌细胞
利用细菌的化学成分、酶系统和核糖体合成出噬菌体的DNA、蛋白质
新合成的DNA、蛋白质组装成很多噬菌体
细菌解体,释放出噬菌体
◇蛋白质没有进入细菌细胞
◇DNA进入到细菌的细胞中
◇DNA才是噬菌体的遗传物质
不能证明蛋白质不是遗传物质
1.艾弗里与赫尔希等人选用细菌或病毒作为实验材料,以细菌或病毒作为实验材料具有哪些优点?
个体小,结构简单,细菌是单细胞生物,病毒无细胞结构,只有核酸和蛋白质外壳,易于观察因遗传物质改变导致的结构和功能的变化。 繁殖快,细菌20-30min就可繁殖一代,病毒短时间内可大量繁殖。
只有DNA是遗传物质吗?
下面这些生物的遗传物质是什么?
烟草花叶病毒(TMV)只含蛋白质和RNA
结论:RNA是烟草花叶病毒的遗传物质
含DNA的病毒:含RNA的病毒:
4.由于大多数生物的遗传物质是DNA,所以说DNA是主要的遗传物质。但肺炎双球菌的转化实验和噬菌体侵染细菌的实验只能证明DNA是遗传物质。
3.在只含RNA的少数病毒(烟草花叶病毒、HIV、SARS、流感、禽流感)中,RNA才作为遗传物质。
2.凡是具有细胞结构的生物,既有DNA,又有RNA,遗传物质是DNA。
1.一切生物的遗传物质是核酸。
DNA是肺炎链球菌、T2噬菌体的遗传物质
RNA是TMV的遗传物质
DNA是细胞结构的生物和DNA病毒的遗传物质
RNA是RNA病毒的遗传物质
DNA是主要的遗传物质
加热杀死的S型细菌中含有转化因子
T2噬菌体侵染大肠杆菌实验
格里菲斯的体内转化实验
1.枯草杆菌具有不同类型,其中一种类型能合成组氨酸。将从这种菌中 提取的某种物质,加入培养基中,培养不能合成组氨酸的枯草杆菌,结 果获得了活的能合成组氨酸的枯草杆菌。这种物质可能是( )
A. 多肽 B. 多糖 C. 组氨酸 D. DNA
2. 赫尔希和蔡斯的噬菌体侵染细菌的实验表明( )
A. DNA是遗传物质
C. 病毒中有DNA,但没有蛋白质
B. 遗传物质包括蛋白质和DNA
D. 细菌中有DNA,但没有蛋白质
5.下列关于生物遗传物质的叙述中,正确的是( ) A.细胞核内的遗传物质是DNA,细胞质内的遗传物质是RNA B.所有生物的遗传物质都是DNA C.具有细胞结构的生物的遗传物质是DNA, 病毒的遗传物质是RNA D.生物的遗传物质是DNA或RNA, 具有细胞结构的生物的遗传物质是DNA
6.下列关于遗传物质的说法,错误的是( ) ①真核生物的遗传物质是DNA ②原核生物的遗传物质是RNA ③细胞核的遗传物质是DNA ④细胞质的遗传物质是RNA ⑤HIV病毒的遗传物质是DNA或RNA A.①②③ B.②③④ C.②④⑤ D.③④⑤
高中生物人教版 (2019)必修2《遗传与进化》第1节 DNA是主要的遗传物质教案配套课件ppt: 这是一份高中生物人教版 (2019)必修2《遗传与进化》<a href="/sw/tb_c4003838_t3/?tag_id=26" target="_blank">第1节 DNA是主要的遗传物质教案配套课件ppt</a>,共32页。PPT课件主要包含了本节聚焦,谁才是遗传物质,问题探讨,思考讨论等内容,欢迎下载使用。
高中生物人教版 (2019)必修2《遗传与进化》第1节 DNA是主要的遗传物质评优课课件ppt: 这是一份高中生物人教版 (2019)必修2《遗传与进化》第1节 DNA是主要的遗传物质评优课课件ppt,共51页。PPT课件主要包含了学习目标,“我们表示怀疑”,基因重组,深入分析,先标记大肠杆菌,噬菌体侵染细菌,积极思考,各种生物的遗传物质等内容,欢迎下载使用。
高中生物第1节 DNA是主要的遗传物质教课内容ppt课件: 这是一份高中生物第1节 DNA是主要的遗传物质教课内容ppt课件,共39页。PPT课件主要包含了遗传物质的探究历程,DNA重组,肺炎双球菌的转化实验,噬菌体侵染细菌实验,DNA是遗传物质等内容,欢迎下载使用。













